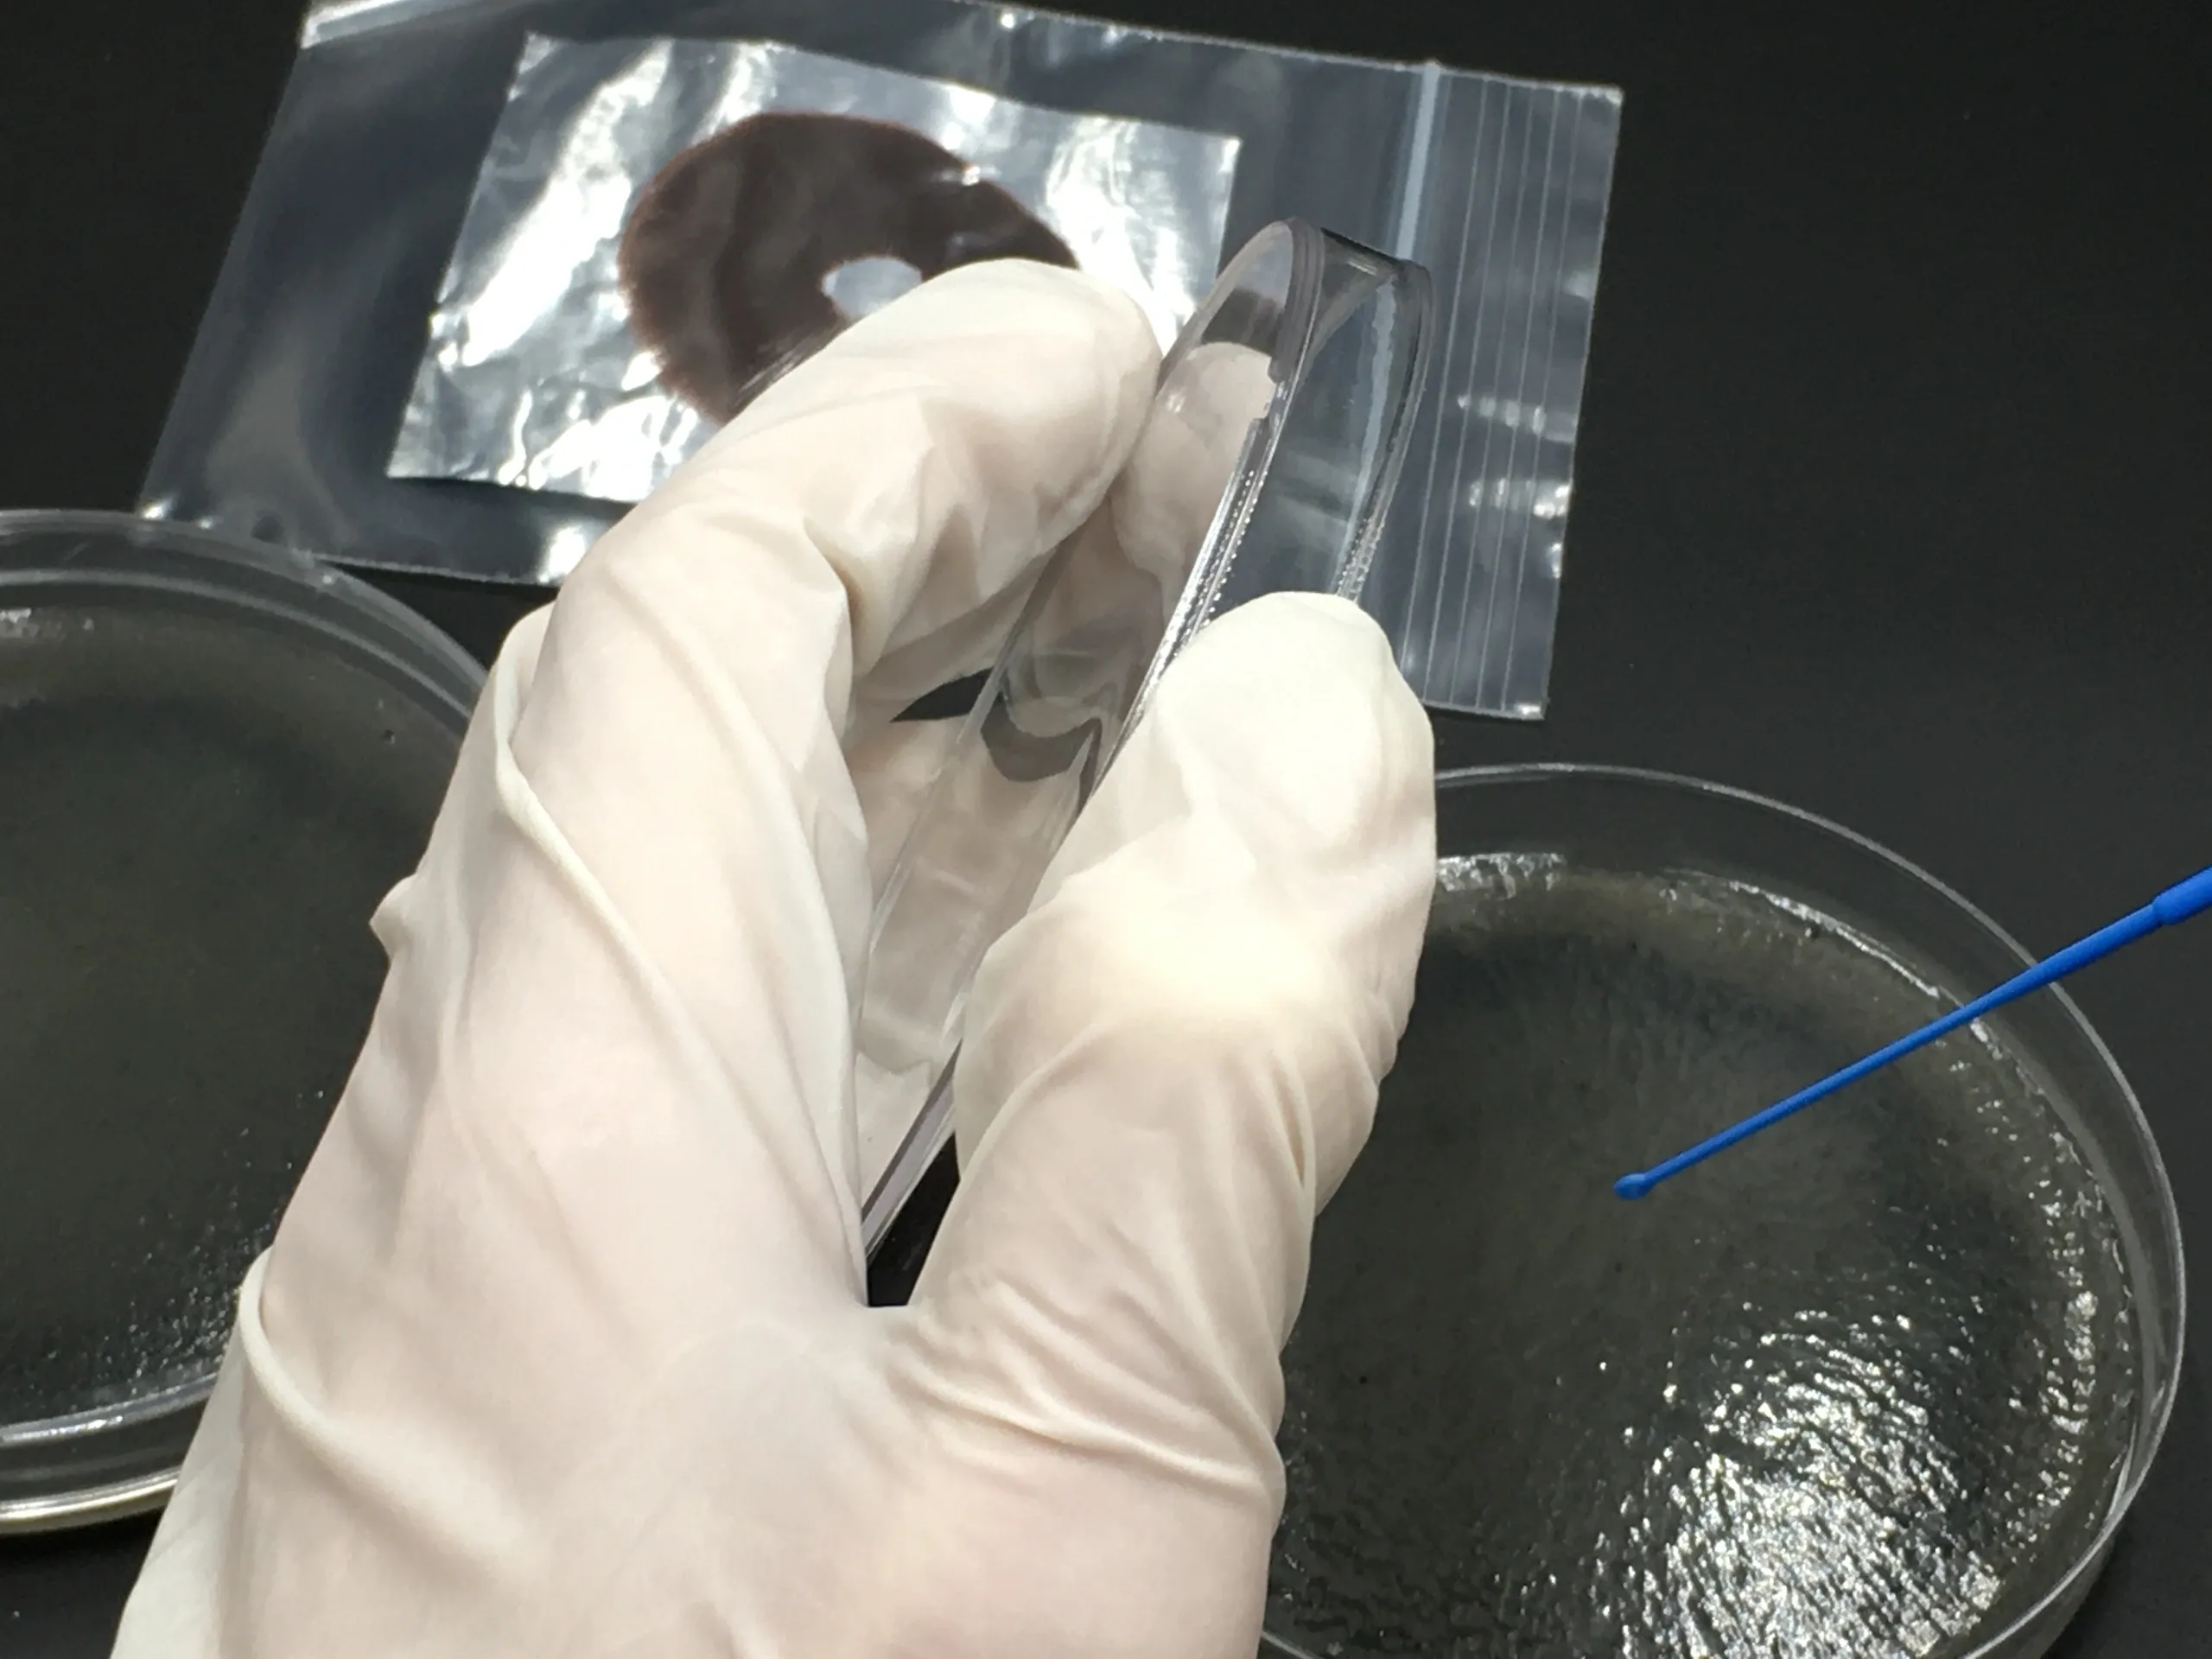
206_original 206_original
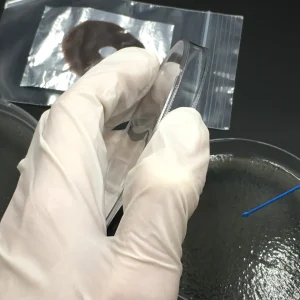
206_original 206_original

Description
Biologix 1µL Disposable Inoculation Loops – Pack of 25
Introducing the ideal tool for precise mycology research: the Biologix 1µL Disposable Inoculation Loops. Designed for seamless spore transfer from spore prints to agar plates, these loops feature a smooth surface for non-damaging streaking. Pre-sterilized by gamma radiation, they ensure contamination-free handling, making them perfect for transferring magic mushroom spores, working with liquid cultures, and other mycological studies. Color-coded for easy identification, they come in a secure zip-seal bag, ready for immediate use.
Why Choose Biologix Inoculation Loops for Mycology?
- Pre-Sterilized: Gamma-irradiated for sterile spore handling and mycological experiments.
- Precision Transfer: Ideal for working with spores, agar wedges, and mycelium samples.
- Contamination-Free: Minimize the risk of contamination when handling delicate fungal cultures.
- Lab Ready: Perfect for professional and hobbyist mycologists.
Key Features for Mycology Research
- Smooth Surface: Perfect for transferring spore solution or mycelium without damaging agar plates.
- Color-Coded: Helps distinguish tools during fungal research.
- Secure Packaging: Keeps tools clean and sterile for immediate use.
To use Biologix 1µL Disposable Inoculation Loops for mycology:
- Ensure Sterility: These loops come pre-sterilized, but always work in a clean, controlled environment.
- Transfer Spores: Dip the loop gently into your spore print, liquid culture, or sample material. The 1µL loop allows precise collection of spore material.
- Streak Agar: Gently glide the loop across the surface of the agar plate in a smooth motion to spread the spores evenly.
- Dispose or Sterilize: Designed for single use, but can be heat-sterilized for re-use by flaming.
This ensures efficient, contamination-free spore transfer.
Enhance your mycology lab with the best tools for spore transfers and agar work. Get fast, secure UK delivery.